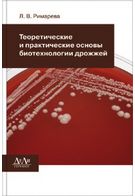

Теоретичні і практичні основи біотехнології дріжджів 8736
Код товару: 8736Паперова книга
-
ISBN
-
Бренд
-
Автор
-
Рік2010
В даний час відкриваються широкі перспективи ефективного використання дріжджових культур у різних біотехнологічних процесах при виробництві спирту, пива, вина, квасу, хліба, харчового білка, біологічно активних харчових добавок. У підручнику подано теоретичні та практичні основи біотехнології спиртових дріжджів, даються основні уявлення про сучасних методах отримання активних рас дріжджів, що володіють новими морфолого-фізіологічними і культуральними властивостями. У книзі узагальнено досягнення сучасної нау-ки в галузі біології, ферментологии і мікробіології дріжджової клітини. Детально висвітлено всі етапи промислового виробництва і застосування дріжджів у спиртовій галузі, а також ферментних препаратів для біокаталізу полімерів зернової сировини в процесі приготування зернового сусла для генерації дріжджів і спиртового бродіння. Особливу увагу приділено питанням вдосконалення біотехнологічних процесів спиртового виробництва, якості зернової сировини та способів ферментативної обробки в залежності від виду зернової культури. Підручник призначений для студентів, які навчаються за спеціальностями "Біотехнологія", "Харчова біотехнологія", "Бродильні виробництва і виноробство" і ін
1'276 ₴
-
Нова ПоштаБезкоштовно від
3'000,00 ₴ -
УкрпоштаБезкоштовно від
1'000,00 ₴ -
Meest ПоштаБезкоштовно від
3'000,00 ₴
Характеристики
- Бренд
- Автор
- КатегоріяТехнічна
- Рік2010
- Сторінок252
- Формат170х240 мм
- ОбкладинкаТверда
Від видавця
В даний час відкриваються широкі перспективи ефективного використання дріжджових культур у різних біотехнологічних процесах при виробництві спирту, пива, вина, квасу, хліба, харчового білка, біологічно активних харчових добавок. У підручнику подано теоретичні та практичні основи біотехнології спиртових дріжджів, даються основні уявлення про сучасних методах отримання активних рас дріжджів, що володіють новими морфолого-фізіологічними і культуральними властивостями. У книзі узагальнено досягнення сучасної нау-ки в галузі біології, ферментологии і мікробіології дріжджової клітини. Детально висвітлено всі етапи промислового виробництва і застосування дріжджів у спиртовій галузі, а також ферментних препаратів для біокаталізу полімерів зернової сировини в процесі приготування зернового сусла для генерації дріжджів і спиртового бродіння. Особливу увагу приділено питанням вдосконалення біотехнологічних процесів спиртового виробництва, якості зернової сировини та способів ферментативної обробки в залежності від виду зернової культури. Підручник призначений для студентів, які навчаються за спеціальностями "Біотехнологія", "Харчова біотехнологія", "Бродильні виробництва і виноробство" і ін
Теоретичні і практичні основи біотехнології дріжджів
1'276 ₴






















Відгуки про Теоретичні і практичні основи біотехнології дріжджів